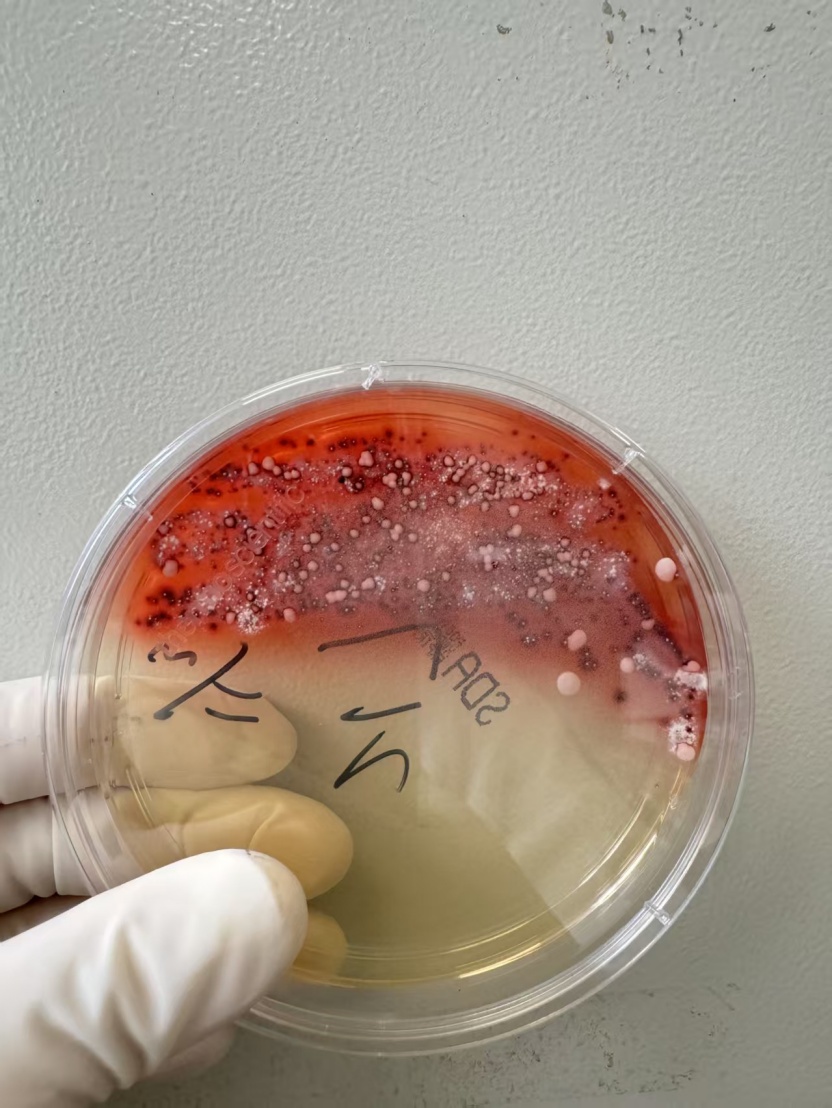
紧急提醒！这种Ⅰ类致癌物，几乎家家都有！

你是否曾留意
在我们的日常居住环境中
可能正悄然滋生着
被世界卫生组织
列为Ⅰ类致癌物的毒素
一旦温度与湿度条件适宜
它便会迅速萌发、生长和繁殖
不仅影响居住的舒适度
更可能对人体健康构成严重威胁
它就是霉菌
2025年4月,浙江杭州一女子整理衣柜后出现发烧、咳嗽的症状,体温最高达40℃。医生问诊得知,该女子整理衣柜时发现柜内长了霉斑,便动手清理,但清理过程中没戴口罩。经检查,最终确诊其感染曲霉菌。

2025年1月,江苏扬州的张大爷为迎接春节开始大扫除,清扫过程中不慎吸入大量灰尘和霉菌孢子,导致哮喘发作。张大爷随即服用了常备的哮喘治疗药物,可症状反而逐渐加重。经检查,张大爷的肺部出现感染,确诊为肺曲霉病。
霉菌还会对身体造成哪些影响?哪些人群更易受到霉菌“攻击”?霉菌爱藏在哪些地方?又该如何清除它们?
霉菌一旦接触就会感染?


红毛癣菌。受访者供图

黄曲霉。受访者供图

烟曲霉。受访者供图
马尔尼菲青霉菌。受访者供图

可别小瞧!
很多疾病由它引起
侵袭呼吸系统

影响胃肠道

发霉食物切掉坏的部分还能吃?
答案是否定的。霉变食物的可见霉斑不过是“冰山一角”,霉菌和毒素早已扩散至内部。因此,即使切除霉变部分,剩余食物也不宜食用。
诱发过敏


北京同仁医院曾对门诊过敏性鼻炎患者统计发现,霉菌是过敏性鼻炎的重要原因之一。
致癌

家中哪些地方易被“攻陷”?
医师介绍,霉菌大量繁殖主要有4个条件:
温度在20-35℃之间;
湿度60%以上;
灰尘、木材、食物残渣等为其提供“营养源”;
通风不畅。
基于霉菌的生存条件,家中以下几个地方更容易成为霉菌的藏匿地。
卫生间
卫生间的墙角、瓷砖缝、水龙头、浴室帘子、浴室密封胶等处,都可能出现霉菌。
洗衣机

冰箱门


空调
空调长期不清洗,其管道和机体内部容易成为霉菌滋生的“重灾区”。
如何远离霉菌?
环境除湿,釜底抽薪

清洁除霉,主动出击


物品防护,细节制胜
书籍、衣物和被褥等易受潮物品应妥善存放,防止受潮发霉,有太阳时应及时拿出晾晒,利用阳光杀菌除霉。若遇连续阴雨天,可使用烘干机或吹风机等,避免物品长时间处于潮湿状态。
临近春节
大扫除时
请注意防护
综合:国家应急广播、央视频、河北交通广播
点击右上角
微信好友
朋友圈

点击浏览器下方“
”分享微信好友Safari浏览器请点击“
”按钮

点击右上角
QQ

点击浏览器下方“
”分享QQ好友Safari浏览器请点击“
”按钮
